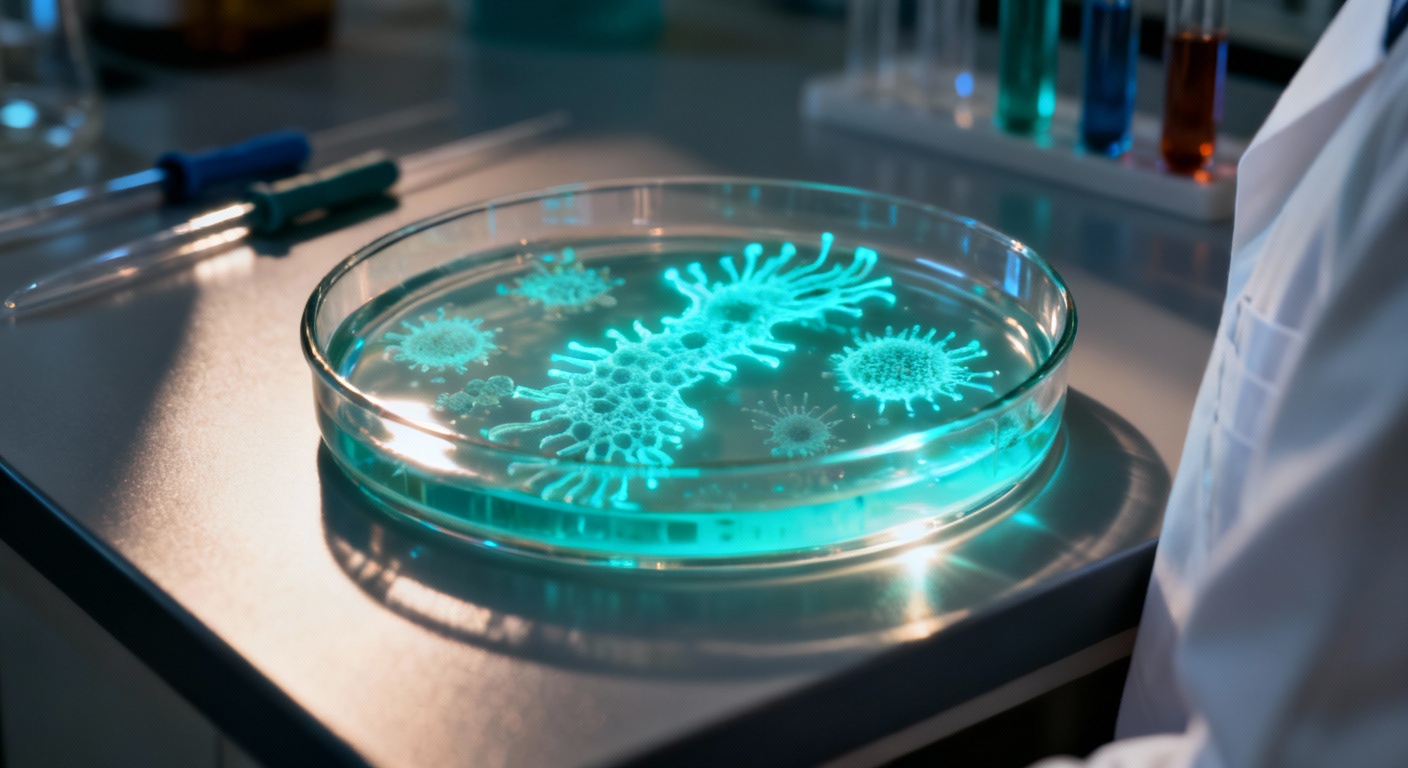

Une découverte fascinante : cette créature mystérieuse qui remet en cause notre définition de la vie
Auteur: Mathieu Gagnon
La frontière floue entre le vivant et l’inerte

Au premier abord, définir ce qu’est la « vie » semble être une tâche plutôt simple, n’est-ce pas ? Des animaux sensibles que nous côtoyons tous les jours jusqu’aux organismes unicellulaires capables de se reproduire, tout ce petit monde est le bienvenu sur le grand arbre de la vie. C’est rassurant, c’est clair. Mais voilà, la nature a horreur des cases trop bien rangées. Il existe des organismes qui viennent chambouler cette compréhension, comme les virus. Parce qu’ils ne grandissent pas vraiment, ne se reproduisent pas seuls et ne fabriquent pas leur propre énergie, on a coutume de les exclure des définitions classiques de la vie. Ils sont là, mais pas tout à fait « vivants » au sens strict.
Cependant, il ne faut pas s’y tromper. Une fois qu’un virus trouve un hôte potentiel à infecter, il devient immensément actif. Il suffit de regarder l’histoire récente ou passée pour s’en convaincre : la grippe espagnole, Ebola, ou plus près de nous, la COVID-19. Ces événements, capables de bouleverser le monde entier, sont le fait d’entités que la biologie hésite pourtant à qualifier de vivantes. C’est tout le paradoxe. La vie est complexe, infiniment plus que nos manuels scolaires ne le laissaient présager, et cette catégorisation controversée entre « vie » et « non-vie » comporte des zones d’ombre, des zones grises où certains organismes semblent défier les attentes des deux camps.
L’étrange cas du Sukunaarchaeum mirabile
C’est ici que l’histoire devient vraiment intéressante, voire un peu déroutante. Récemment, des scientifiques ont mis la main sur une nouvelle créature perchée exactement sur cette ligne de crête, au bord de la catégorie « vie ». Dans un papier publié sur le serveur bioRxiv, une équipe de chercheurs basés au Canada et au Japon a détaillé comment ils ont identifié une nouvelle entité cellulaire. Ce n’est pas tous les jours qu’on tombe sur quelque chose qui remet en question les bases mêmes de la biologie cellulaire, vous en conviendrez.
Cette entité porte un nom assez singulier : « Sukunaarchaeum mirabile ». Pour la petite histoire, elle a été nommée d’après une divinité de la mythologie japonaise connue pour sa petite taille. Et le nom est bien choisi ! L’équipe de recherche a conclu qu’il s’agit bien d’une forme de vie, mais elle est étrange. Elle contient les gènes nécessaires pour créer ses propres ribosomes et son ARN messager. C’est un détail technique, mais crucial : c’est quelque chose que votre virus typique est totalement incapable de faire. En général, le virus doit « pirater » la machinerie de son hôte pour faire cela.
Pourtant, le Sukunaarchaeum mirabile n’est pas tout à fait autonome non plus. Comme un virus, il décharge certaines fonctions biologiques sur son hôte potentiel. On dirait qu’il a choisi le meilleur des deux mondes, ou peut-être le plus paresseux, ça dépend du point de vue. Il semble singulièrement obsédé par une seule chose : se répliquer, encore et encore.
Un génome minuscule qui défie les statistiques

Ce qui frappe aussi avec cette créature, c’est sa taille génétique. Son génome est d’une petitesse surprenante. On parle ici de seulement 238 000 paires de bases. Pour vous donner une idée de l’échelle, c’est à peu près la moitié de la taille du génome archéen le plus petit connu jusqu’alors. C’est minuscule. C’est comme si cet organisme avait décidé de voyager léger, en ne gardant que le strict minimum pour survivre et se dupliquer, tout en empruntant le reste à ses voisins.
Cette découverte complique singulièrement la tâche des biologistes. Jusqu’à présent, nous aimions bien tracer une ligne : d’un côté les virus (parasites absolus, non vivants), de l’autre les cellules (autonomes, vivantes). Mais voilà que le Sukunaarchaeum mirabile brouille les pistes. Il externalise, certes, comme un virus, mais il possède sa propre machinerie de production interne pour l’ARN, comme une cellule. C’est un hybride, un « entre-deux » qui nous force à reconsidérer nos certitudes.
Conclusion : Une nature toujours plus surprenante

Au final, qu’est-ce que cela nous apprend ? Probablement que nous avons encore beaucoup de chemin à faire pour comprendre la complexité du monde microscopique. Cette créature, découverte aux franges de la vie, nous rappelle que la nature ne suit pas toujours nos règles ou nos définitions humaines. Elle s’adapte, elle triche parfois, elle trouve des chemins de traverse.
Alors que nous continuons d’explorer l’infiniment petit, il est fort probable que d’autres entités comme le Sukunaarchaeum mirabile surgissent, nous obligeant, encore et encore, à réécrire nos manuels de biologie. C’est un peu vertigineux, mais c’est aussi ce qui rend la science si passionnante, non ?
Ce contenu a été créé avec l’aide de l’IA.










